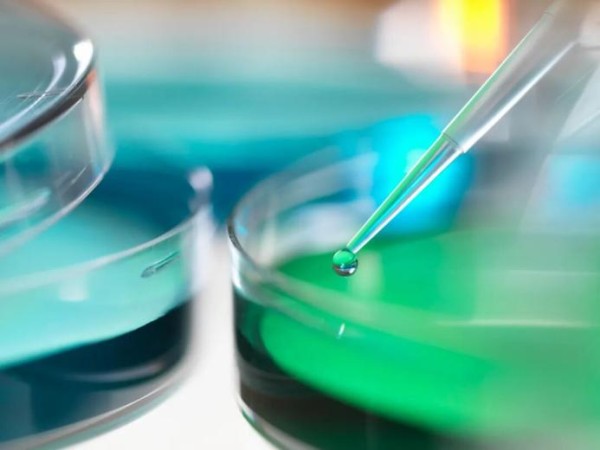

女子误踩氢氟酸不幸去世,放了10年的酸这么厉害?接触了怎么办?
[教育] 孩子不听话怎么办? #生活知识# #教育子女#
2025年9月9日,浙江杭州的一女子陪同朋友在户外垦荒种菜时,不小心踩到一个废弃化学品容器,当时就出现剧烈疼痛,虽然随行同伴做了紧急处理,用水清洗后,紧急送医,但到医院才知道,女子踩到的是剧毒物质氢氟酸,最终医治无效不幸离世。

后经警方调查,18日发出通告,怀疑这桶氢氟酸是2015年在事发地居住的一名外墙清洗工遗弃在此处的。
十年前的一桶氢氟酸,酿成了十年后的一场惨剧,氢氟酸到底是什么,为何这么毒?
俗称“化骨水”:一滴可致命
氢氟酸是一种工业上使用的非常广泛的无机酸,透明无色,有刺激性气味、易挥发,具有强烈的刺激性和腐蚀性。
但和它的众多表亲,比如我们熟知的盐酸、硫酸不同,氢氟酸对人体的健康危害极大,武侠剧里出现的“化骨水”说的就是它,是最危险的化学品之一。
▶ 氢氟酸的渗透性极强,哪怕是很低的浓度,也可以透过皮肤粘膜、呼吸道、消化道深入骨髓和血液,短时间内小面积的接触也会导致烧伤剧痛;
▶ 6-24小时脂肪肌肉液化性坏死,水疱含果酱色液体;
▶ 到最后阶段,氟离子会“偷走”血液中的钙,导致剧烈骨痛,严重者骨质脱钙坏死,甚至于导致低钙血症,引发心脏骤停等致命问题。
这种剧毒物质广泛用于实验室、半导体行业,玻璃蚀刻、除锈、制造制冷剂等。因此从事以下几类职业的人员均属于高危暴露群体:
实验室操作员
电子厂蚀刻工人
玻璃雕刻师
空调维修工
珠宝首饰加工者
致命警示:接触少≠毒性低
具体看浓度:7毫升无水氟化氢可结合成人全身游离钙;2.5%体表面积烧伤(约两手掌大小)或摄入1.5克氢氟酸即可致命。
氢氟酸的自救指南
如果不幸接触到氢氟酸,记住:时间就是生命:
1、立刻冲洗
脱去污染衣物首饰、鞋袜等,第一时间用大量清水冲洗至少30分钟,可以最大程度的冲淡酸液。
2、临时急救
清洗后可以用氢氟酸的急救用品,比如葡萄糖酸钙凝胶、六氟灵,中和氢氟酸,尽量减轻组织的损伤。
3、尽快就医
拨打120,迅速送往正规医院处理。氢氟酸的伤害会持续,只有到了医院才能彻底处理氟离子中毒。
生活中有毒的“隐形杀手”!
除了氢氟酸,在我们的日常生活中使用的玻璃瓷砖清洁剂、金属除锈剂中,也暗藏了这位“隐形杀手”。尤其是那些宣传可以"强力去污"、"顽固污渍克星"的产品。

1.强酸强碱类
代表物质:硫酸、盐酸、氢氧化钠等;
生活场景:洁厕灵、管道疏通剂、废旧蓄电池等;
危害:强腐蚀性,接触皮肤可致灼伤、组织坏死,吸入气体可能损伤呼吸道。
2.含氯消毒剂
代表物质:84消毒液、漂白粉。
生活场景:用于日常消毒和衣物漂白。
危害:过量吸入损伤呼吸道,与酸性物质混合会产生有毒氯气,引发化学性肺炎甚至窒息。
3.农药类
代表物质:有机磷、拟除虫菊酯等
生活场景:农田及家庭杀虫剂中常见。
危害:接触或吸入可能中毒,出现头晕、呕吐、呼吸困难等症状,严重时危及生命。
4.重金属化合物
代表物质:汞、铅、砷等。
生活场景:体温计、老旧油漆、不合格玩具及食品中可能含有。
危害:在体内蓄积后损害神经、消化和造血系统,影响智力发育和肝肾功能。

如果需要使用以上这些物品,需要注意:
① 看标签:购买清洁剂等产品时,留意成分表。
② 戴手套:使用化学品时,务必戴上橡胶手套。
③ 不乱扔:废弃化学品请咨询当地环保部门,按规定处理。
悲剧的发生令人痛心,但却给我们敲响了警钟,面对生活中的潜在危险源,一定要掌握一定的急救知识,提高防范意识。
文章作者:陌陌
图片来源:摄图网
原标题:《女子误踩氢氟酸不幸去世,放了10年的酸这么厉害?接触了怎么办?》
阅读原文
网址:女子误踩氢氟酸不幸去世,放了10年的酸这么厉害?接触了怎么办? https://www.yuejiaxmz.com/news/view/1363329
相关内容
家庭清洁必读:氢氟酸的潜在危险与安全使用指南氯氟氰菊酯农药能和磷酸=氢钾混用吗?
高锰酸钾染色怎么去掉?
加了脱氢乙酸钠=夺命“月饼”?
日常清洁看到酸和碱就害怕?了解真实的酸和碱,让你安心使用
生活用品中蕴含着丰富的化学知识.用品小苏打管道通有效成分NaHCO3NaOH(1)小苏打能用于治疗胃酸过多症.用化学方程式表示其原因 .(2)管道通在使用时禁止与皮肤接触.其原因是 . NaHCO3 +HCl == NaCl + H2O + CO2↑氢氧化钠具有强烈的腐蚀性 [解析] (1)小苏打是碳酸氢钠的俗称.胃酸的主要成分是盐酸.小苏打与胃酸反应生成氯化钠.水� 题目和参考答案——青夏教育精英家教网——
酸性=酸洗?
为什么瓷砖会有酸臭味 瓷砖地板发出酸臭味怎么办
玻璃发霉擦不掉怎么办
“化骨水”杭州夺命,日常生活中这些危化品你要小心啦

